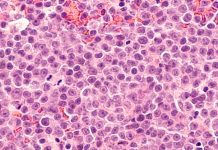

haematology Related News
Researchers suggest changes to haemophilia treatment
Findings from two University Hospital Bonn studies could lead to significant changes in haemophilia treatment.
Haemophilia A, which almost exclusively affects males, is the most...
Cellular discovery in lymphomas could improve blood cancer treatment
New insights on the workings of aggressive lymphomas could lead to earlier cancer detection and improvements in treatment, researchers say.
In a study led by...
Setting the new standard for managing surgical bleeding and organ leakage
GATT Technologies has developed a game-changing solution targeted to set the new standard in managing bleeding and organ leakage.
Managing surgical bleeding and preventing organ...
Project investigating COVID-19 blood vessel inflammation receives grant
A new project that will investigate the role of inflammation in blood vessel damage in COVID-19 patients has received a grant from Heart Research...
Did you know that the market for blood glucose monitoring is expected to rise?
According to Data Bridge Market Research, the blood glucose monitoring system market is forecasted to increase from $13.9bn in 2018 to an estimated value...
bluebird bio announces launch of beta thalassaemia gene therapy in Germany
Zynteglo is a one-time gene therapy that addresses the underlying genetic cause of TDT and offers patients the potential to become transfusion independent.
The one-time...
Cardiologists establish how e-cigarettes damage the brain, blood vessels and lungs
Cardiologists have issued a stark warning about the dangers of how e-cigarettes damage the brain, blood vessels and lungs, particularly for young people.
The study, published...
Lower blood lipids: can you eat a cheeseburger and have a strong heart?
A breakthrough in the battle to, lower blood lipids, reduce cholesterol and Triglycerides comes with weight loss as a bonus.
CannaLean had developed CLC, a...
Diagnosing heart disease just got easier with a new imaging tool
Reduced blood flow to the heart muscle is the leading cause of death in the Western world, and now researchers are first to develop...
What do you know about Elfi-Tech and their Finger Port device?
Elfi-Tech’s Dr Ilya Fine talks Finger Port, the innovative device that acts as your own personal health station, providing unparalleled ease of use at...